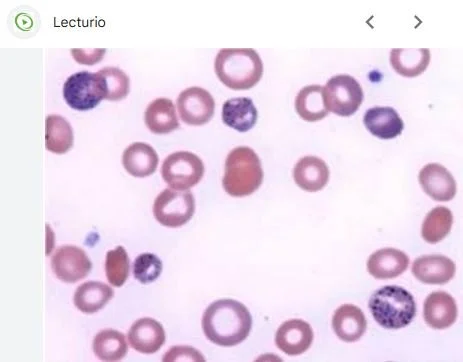

A 39 y.o. female with a history of muscle disease comes in complaining of worsening weakness and R radial nerve palsy.
She is found to have a microcytic hypochromic anemia . Her slide appears below
What do you notice on the slide?
Our patient has basophilic stippling causing the doctor to take a more careful history. She had recently returned from India where she had been taking Ayruvedic herbs for her weakness. One of the herbs was found to have a lead level of 50.4 mg/gram. She had lead poisoning.
Lead poisoning has been implicated in some patients with mental illness
While lead has been thought to mainly be a danger in children and people taking herbal supplements, recently it has been shown to be in high concentrations in some plant based protein powders and shakes. This has been especially important since recent guidelines advise increasing protein intake in the elderly to prevent muscle wasting. Older adults store lead in their bones and it can be released at a later date when osteoporosis occurs. A combination of increased intake and lead released from aging bones can lead to high lead levels in the elderly.
PHYSIOLOGY OF LEAD
Why basophilic stippling?
Lead interferes with the production of red blood cells (erythropoiesis). It inhibits the enzyme ribonuclease, which is responsible for breaking down ribosomes (small particles involved in protein synthesis). As a result, ribosomes accumulate in the RBCs, causing the basophilic stippling.
Why does lead cause neurologic deficits?
Lead mimics calcium and interferes with neural transmission. It disrupts the myelin sheath of neurons. Lead also damages mitochondria overwhelming their ability to clear glutamate which kills cells when it is present in excessive amounts.
Why do plant based proteins create more of a problem than animal ones?
Plant based protein products have been shown to contain high levels of lead as well as herbal supplements. Lead gets into plant-based products because plants absorb heavy metals from contaminated soil and it is concentrated in the drying process.
Lead poisoning is also a risk in the production of moonshine where metal containers with old solder and brass fittings may be used.
It is important in taking a history in a patient with microcytic anemia to ask about exposures. The usual sources of lead at one time were lead paint and leaded gasoline. Moonshine makers were also at risk. Today, traditional herbal medicines, ceramic paints, cosmetics and jewelry making can be the cause of lead poisoning.
For example, a case of lead poisoning was described in a woman who brought a ceramic mug back from Greece. She regularly drank lemon instant-tea from it over the next 2.5 months. She developed lead poisoning and it was traced to the cup.
Beware Greeks bearing gifts—Virgil
Our patient was treated with EDTA to chelate the lead in 16 infusions and then with oral meds. Her radial nerve palsy resolved.
FUN FACT
Lead appears as Pb on the periodic table because the Latin name for it was plumbum. Since Roman pipes were made of lead, it became the origin of our word plumber.
Martineau P. Protein powders and shakes contain high levels of lead. CR Oct 14, 2025.
Vig E, Hu H. Lead toxicity in older adults Review J Am Geriatr Soc. 2000 Nov;48(11):12-1-6.
Eldhose R, Viggeswarpu S, Jambugulam M. Unmasking herbal medication-induced lead poisoning in a geriatric patient with gastrointestinal symptoms. BMJ Case Rep 2023 Dec 12;16(12):e258065.
Autenrieth T, Schmidt T, Habscheid W Lead poisoning caused by a Greek ceramic cup. Case Reports Dtsch Med Wochenschr. 1998 Mar 20;123(12):358-0.
Ibrahim A, Larif A. Adult lead poisoning from a herbal medicine. Saudi Med J. 2002 May;23(5):591-3.
Seide R, Engelhart S, Farber H, et al. Severe lead poisoning due to Ayurvedic Indian plan medicine. Case Reports Dtsch Med Wochenschr. 2003 Nov 14;128(46):2418-20.
A poison kiss A report in 2007 reported on lead in lipstick. L’Oreal contained 7.0 ppm of lead in a 2022 report.